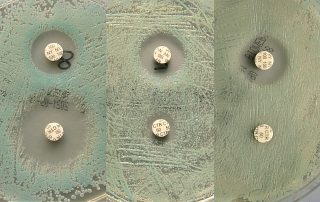

Wann entsteht Endometriose – gibt es Risikofaktoren?
Die Endometriose ist eine gutartige östrogenabhängige Erkrankung der geschlechtsreifen Frau, deren Ätiologie immer noch nicht zweifelsfrei und eindeutig wissenschaftlich belegt ist. Die Prävalenz von circa 10% der geschlechtsreifen Frauen unterstreicht die Relevanz in der täglichen Praxis. Gemeinsamkeiten von Endometriosepatientinnen legen nahe, dass es Risikofaktoren gibt, die die Entstehung der Erkrankung eher begünstigen oder die eher vor der Entstehung schützen können.